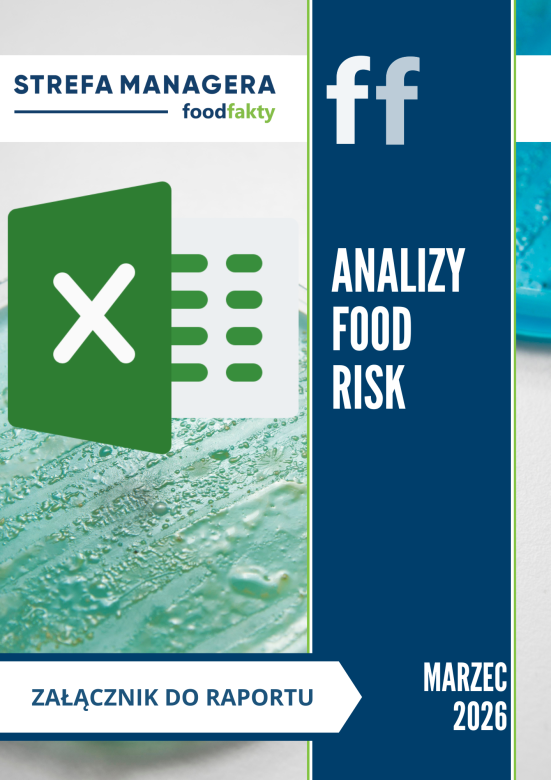
Raport RISK - marzec 2026 - załącznik

Wyrażam zgodę na przetwarzanie moich danych osobowych podanych w formularzu rejestracyjnym przez firmę Prokonsument Sp. z o.o.
z siedzibą w Warszawie przy ul. Serwituty 25 będącą właścicielem portalu FoodFakty.pl w celach marketingowych i promocyjnych,
w szczególności powiadomienia o nowych publikacjach, biuletynach i wydarzeniach dotyczących usług oferowanych przez portal
jak również kontrahentów portalu; realizacji obowiązków związanych z wymogami w zakresie niezależności, zarządzania ryzykiem
i jakością;Podanie adresu e-mail oznacza zgodę na otrzymywanie drogą elektroniczną na wskazany adres informacji handlowej
w rozumieniu art. 10 ust. 1 ustawy z dnia 18 lipca 2002 roku o świadczeniu usług drogą elektroniczną od
Prokonsument Sp. z o.o. z siedzibą w Warszawie, 02-233, ul Serwituty 25, NIP 5260201821, który jest wydawcą portalu FoodFakty.pl.
Administratorem podanych danych osobowych jest Prokonsument Sp. z o.o. z siedzibą w Warszawie na ul. Serwituty 25 .
Dane osobowe przechowywane są przez okres 3 lat. Przysługuje Pani/Panu prawo dostępu do treści oraz poprawiania swoich danych osobowych.
Ma Pani/Pan prawo w dowolnym momencie odwołać (wycofać) wyrażone zgody. Odwołanie (wycofanie) zgody nie wpływa na zgodność z prawem przetwarzania,
którego dokonano na podstawie zgody przed tym faktem.
Ma Pan/Pani prawo wniesienia skargi do właściwego organu nadzorczego w zakresie ochrony danych osobowych gdy uzna Pani/Pan,
iż przetwarzanie danych osobowych Pani/Pana dotyczących narusza przepisy ogólnego Rozporządzenia o ochronie danych osobowych
z dnia 27 kwietnia 2016 r. Podane przez Pana/Panią dane osobowe są warunkiem zrealizowania świadczenia.
Więcej informacji zawarte w: